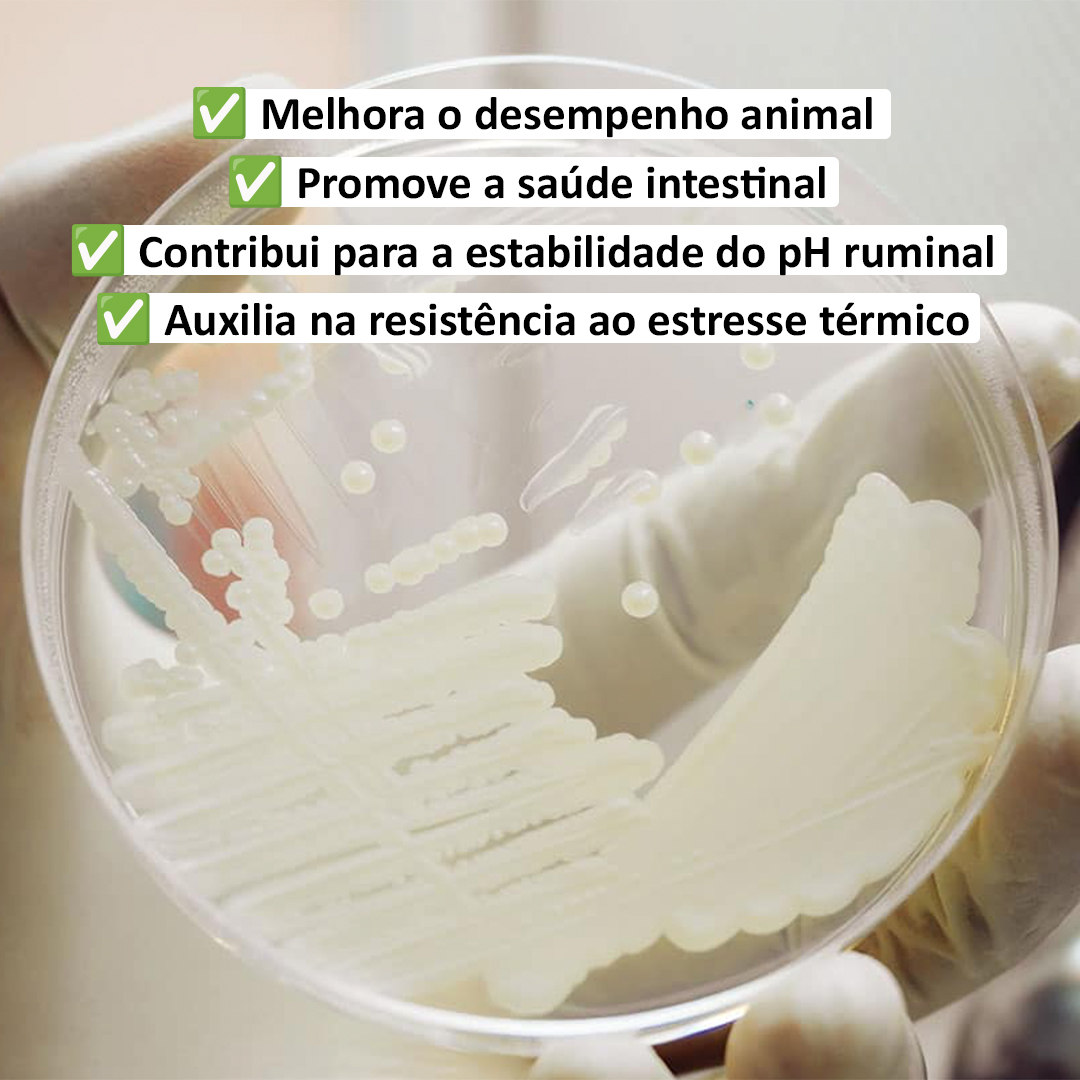
Procreatin 7 - Probióticos de levedura concentrado com alto teor de levedura viva Saccharomyces cerevisiae 4 Procreatin 7 - Probióticos de levedura concentrado com alto teor de levedura viva Saccharomyces cerevisiae - Imagem 4
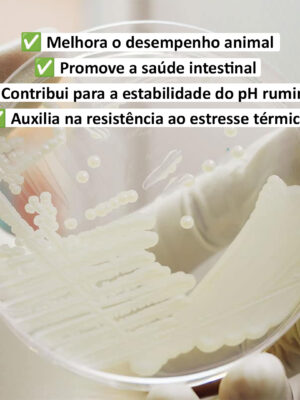

Procreatin 7
A Procreatin 7 é seca através de processos proprietários patenteados especiais, que mantêm uma alta contagem de células. Cada lote produzido é analisado para garantir conformidade com os padrões microbiológicos, físicos e químicos e cumprir a garantia mínima de 1,5 x 1010 UFC por grama de produto. A Procreatina 7 estabiliza o rúmen, aumenta o pH do rúmen e aumenta os rendimentos de componentes do leite.
Procreatin 7 é estável em premixes minerais. Não é ideal para uso em rações peletizadas. Ele sobreviverá em rações fareladas e em TMR.
Embalagem
- Saco a vácuo laminado em caixa de 10 kg.
Validade
Este produto tem validade de dois anos se armazenado em local fresco e seco em sua embalagem original.
Dosagem
Ruminantes (g/cabeça/dia)
- Vacas leiteiras 3 – 10
- Gado de corte 1 – 5
- Bezerros 0.5 – 2
- Cordeiro para engorda 0.5 – 2
- Cabra e Ovinos Leiteiros 0.5 – 2
Suínos (kg/ton de ração)
- Matrizes 0.5 – 1
- Matriz gestante 0,35-1
- Matriz lactante 0.5 – 1
- Leitão (desmamado) 1 – 1.5
- Suíno para engorda (inicial) 0.5 – 1
- Suíno para engorda
- (crescimento e final) 0,125-0,5
Aves (kg/ton de ração)
- Animais jovens 0.5 – 1
- Galinha poedeira 0.35 – 0.5
- Frango de corte 0.5 – 1
- Matrizes 0.5 – 1
- Matriz gestante 0,35-1
- Matriz lactante 0.5 – 1
Outras espécies
- Equino 5-15g/cabeça/dia
- Coelho 0.5 – 2 kg/ton